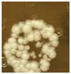
Cosmetics 05 00043 i004
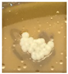
Cosmetics 05 00043 i008

Development of Antidandruff Shampoo from the Fermented Product of Ocimum sanctum Linn.
Abstract
1. Introduction
2. Materials and Methods
2.1. Plant Materials
2.2. Microorganisms
2.3. Preparation of Extracts %
2.4. Determination of Antifungal Susceptibility Testing of the Fermented Product of O. sanctum
2.5. Determination of Organic Acids Content by High Performance Liquid Chromatography (HPLC)
2.6. Determination of Total Soluble Protein Content
2.7. Development of Shampoo Formulations
2.8. Characterization of Shampoo Formulations
2.8.1. Physical Appearance
2.8.2. Determination of Foaming Ability and Foam Stability
2.8.3. pH Measurement
2.8.4. Determination of Wetting Time
2.8.5. Determination of Solid Content
2.8.6. Viscosity Measurement
2.9. Stability Test of Shampoo Formulations
2.10. Evaluation of Conditioning Performance of Shampoo Formulations
2.11. Determination of Antifungal Susceptibility Testing of Shampoo Containing the Fermented Product of O. sanctum by Agar Well Diffusion Method
2.12. Statistic Analysis
3. Results and Discussion
3.1. Yield of the Fermented Product of O. sanctum
3.2. Antifungal Susceptibility Testing of the Fermented Product of O. sanctum
3.3. Organic Acids and Total Soluble Protein Content of the Fermented Product
3.4. Development of the Shampoo Formulation
3.5. Evaluation of Conditioning Performance of Shampoo Formulation
3.6. Antifungal Susceptibility Testing of Shampoo Containing the Fermented Product of O. sanctum
4. Conclusions
Author Contributions
Funding
Acknowledgments
Conflicts of Interest
References
- Chandran, S.; Vipin, K.V.; Augusthy, A.R.; Lindumol, K.V.; Shirwaikar, A. Development and evaluation of antidandruff shampoo based on natural sources. J. Pharm. Phytother. 2013, 1, 2321–5895. [Google Scholar]
- Xu, Z.; Wang, Z.; Yuan, C.; Liu, X.; Yang, F.; Wang, T.; Wang, J.; Manabe, K.; Qin, O.; Wang, X.; et al. Dandruff is associated with the conjoined interactions between host and microorganisms. Sci. Rep. 2016, 6, 24877. [Google Scholar] [CrossRef] [PubMed]
- Alpert, A.; Altenburg, M.; Bailey, D. Milady’s Standard Cosmetology; Cengage Learning: New York, NY, USA, 2002; pp. 221–222. ISBN 1-56253-880-2. [Google Scholar]
- Gupta, A.K.; Batra, R.; Bluhm, R.; Boekhout, T.; Dawson, T.L. Skin diseases associated with Malassezia species. J. Am. Acad. Dermatol. 2004, 51, 785–798. [Google Scholar] [CrossRef] [PubMed]
- Bulmer, A.C.; Bulmer, G.S. The antifungal action of dandruff shampoos. Mycopathologia 1999, 147, 63–65. [Google Scholar] [CrossRef] [PubMed]
- Das, S.K.; Vasudevan, D.M. Tulsi: The Indian holy power plant. Nat. Prod. Rad. 2006, 5, 279–283. [Google Scholar]
- Rana, M.M.; Sayeed, M.A.; Nasrin, S.; Islam, M.; Rahman, M.M.; Alam, M.F. Free radical scavenging potential and phytochemical analysis of leaf extract from Ocimum sanctum Linn. J. Agric. Sci. Technol. 2015, 11, 1615–1623. [Google Scholar]
- Basak, P.; Mallick, P.; Mazumder, S.; Verma, A.S. Assessment of antioxidant, anti-inflammatory, anti-cholinesterase and cytotoxic activities of tulsi (Ocimum sanctum) leaves. Adv. Pharmacol. Toxicol. 2014, 15, 19–29. [Google Scholar]
- Venturi, F.; Sanmartin, C.; Taglieri, I.; Andrich, G.; Zinnai, A. A Simplified Method to Estimate Sc-CO2Extraction of Bioactive Compounds from Different Matrices: Chili Pepper vs. Tomato By-Products. Appl. Sci. 2017, 7, 361. [Google Scholar] [CrossRef]
- Venturi, F.; Sanmartin, C.; Taglieri, I.; Nari, A.; Andrich, G.; Terzuoli, E.; Donnini, S.; Nicolella, C.; Zinnai, A. Development of Phenol-Enriched Olive Oil with Phenolic Compounds Extracted from Wastewater Produced by Physical Refining. Nutrients 2017, 9, 916. [Google Scholar] [CrossRef] [PubMed]
- Balakumar, S.; Rajan, S.; Thirunalasundari, T.; Jeeva, S. Antifungal activity of Ocimum sanctum Linn. (Lamiaceae) on clinically isolated dermatophytic fungi. Asian Pac. J. Trop. Med. 2011, 4, 654–657. [Google Scholar] [CrossRef]
- El-Soud, N.H.A.; Deabes, M.; El-Kassem, L.A.; Khalil, M. Chemical composition and antifungal activity of Ocimum basilicum L. essential oil. Open Access Maced. J. Med. Sci. 2015, 3, 374–379. [Google Scholar] [CrossRef] [PubMed]
- Gunendren, M.; Nordin, S.S.; Ramachandran, M.R.; Samad, N.A. Effect of Ocimum sanctum (Tulsi) aqueous leaf extract on prothrombin time (PT), activated partial thromboplastin time (APTT) and thrombin time (TT) of human plasma. J. Biomed. Clin. Sci. 2017, 2, 62–68. [Google Scholar]
- Sirilun, S. Fermentation Kinetics of Morinda citrifolia linn and Antimicrobial Activity of Its Products. Ph.D. Thesis, Chiang Mai Univercity, Chiang Mai, Thailand, 23 September 2005. [Google Scholar]
- Chaiyasut, C.; Kruatama, C.; Sirilun, S. Breaking the spores of Ganoderma lucidum by fermentation with Lactobacillus plantarum. Afr. J. Biotechnol. 2010, 9, 7379–7382. [Google Scholar]
- Iatta, R.; Immediato, D.; Montagna, M.T.; Otranto, D.; Cafarchia, C. In vitro activity of two amphotericin B formulations against Malassezia furfur strains recovered from patients with bloodstream infections. Med. Mycol. 2015, 53, 269–274. [Google Scholar] [CrossRef] [PubMed]
- Lowry, O.H.; Rosebrough, N.J.; Farr, A.L.; Randall, R.J. Protein measurement with the Folin phenol reagent. J. Biol. Chem. 1951, 193, 265–275. [Google Scholar] [PubMed]
- Al Badi, K.; Khan, S.A. Formulation, evaluation and comparison of the herbal shampoo with the commercial shampoos. Beni-Suef Univ. J. Basic Appl. Sci. 2014, 3, 301–305. [Google Scholar] [CrossRef]
- Manikar, A.R.; Jolly, C.I. Evaluation of commercial herbal shampoos. Int. J. Cosmet. Sci. 2000, 22, 385–392. [Google Scholar] [CrossRef] [PubMed]
- Boonme, P.; Pakpayat, N.; Yotmanee, K.; Kunlawijitrungsee, S.; Maneenuan, D. Evaluation of Shampoos Containing Silicone Quaternary Microemulsion. J. Appl. Pharm. Sci. 2011, 1, 59. [Google Scholar]
- Dey, T.B.; Kuhad, R.C. Enhanced production and extraction of phenolic compounds from wheat by solid-state fermentation with Rhizopus oryzae RCK2012. Biotechnol. Rep. 2014, 4, 120–127. [Google Scholar]
- Zhang, Y.; Zhou, L.; Ma, W.; Shi, X.; Zhang, H.; Shi, X. Bidirectional solid fermentation using Trametes robiniophila Murr. for enhancing efficacy and reducing toxicity of rhubarb (Rheum palmatum L.). J. Tradit. Chin. Med. Sci. 2017, 4, 306–313. [Google Scholar] [CrossRef]
- Wu, T.; Wang, N.; Zhang, Y.; Xu, X. Advances in the study on microbial fermentation and transformation of traditional Chinese medicine. Afr. J. Microbiol. Res. 2013, 7, 1644–1650. [Google Scholar]
- Sreelatha, G.L.; Babu, U.V.; Sharath Kumar, L.M.; Soumya, K.; Sharmila, T. Investigation on biochemical characterisation and in vitro antifungal efficacy of plant extracts on Malassezia furfur. Int. J. Pharma Bio Sci. 2015, 6, 1027–1041. [Google Scholar]
- Cleveland, J.; Montville, T.J.; Nes, I.F.; Chikindas, M.L. Bacteriocins: Safe, natural antimicrobials for food preservation. Int. J. Food Microbiol. 2001, 71, 1–20. [Google Scholar] [CrossRef]
- Baran, R.; Maibah, H.I. Cosmetic dermatology in children. In Text Book of Cosmetic Dermatology, 2nd ed.; CRC Press: London, UK, 1998; pp. 507–508. ISBN 1853174785. [Google Scholar]
- Dias, M.F.R.G.; Almeida, D.A.M.; Cecato, P.M.R.; Adriano, A.R.; Pichler, J. The shampoo pH can affect the hair: Myth or reality. Int. J. Trichol. 2014, 6, 95. [Google Scholar] [CrossRef] [PubMed]
- Kinnunen, T.; Koskela, M. Antibacterial and antifungal properties of propylene glycol, hexylene glycol, and 1,3-butylene glycol in vitro. Acta Derm. Venereol. 1991, 71, 148–150. [Google Scholar] [PubMed]
- Crider, K.; Luciow, C.; Fuls, J.L.; Rodgers, N.D. Antibacterial Composition with Low Amounts of Surfactant and Antibacterial Actives. U.S. Patent No. 9,131,682, 15 September 2015. [Google Scholar]
- Curtis, M.A. Antimicrobial Composition. U.S. Patent No. 7,754,770, 13 July 2010. [Google Scholar]
- Moen, H.K.; Cunningham, C.T.; Hoffman, D.R.; Wenzel, S.W. Antimicrobial Cleansing Compositions. U.S. Patent No. 9,232,790, 12 January 2016. [Google Scholar]
- Colomer, A.; Pinazo, A.; Manresa, M.A.; Vinardell, M.P.; Mitjans, M.; Infante, M.R.; Pérez, L. Cationic surfactants derived from lysine: Effects of their structure and charge type on antimicrobial and hemolytic activities. J. Med. Chem. 2011, 54, 989–1002. [Google Scholar] [CrossRef] [PubMed]

| Ingredient | Function | Formulation (% w/w | |||||||
|---|---|---|---|---|---|---|---|---|---|
| A | B | C | D | E | F | G | H | ||
| Sodium laureth sulfate (70%) (Texapon N70) | Detergent | - | 12 | 20 | 12 | 12 | 15 | 8 | 15 |
| Sodium laureth sulfate (28%) (Texapon N8000) | Detergent | 10 | - | 5 | - | - | - | 10 | 5 |
| Cocamide diethanolamine (Com KD) | Foam builder, thickening agent | 15 | 5 | 5 | 5 | 5 | 10 | 12 | 3 |
| Cetrimonium chloride (CT 429) | Detergent | 5 | 3 | 3 | 3 | 3 | 3 | 3 | 3 |
| Cocamidopropyl betaine (55AB) | Detergent | 8 | 10 | 8 | 8 | 8 | 8 | 7 | 5 |
| Cetyl alcohol | Emollient, opacifying agent | - | - | - | - | - | - | 3 | - |
| Propylene glycol | Humectant | 1.5 | - | 1 | 1 | 1 | 1 | 1.5 | 1 |
| Glycerin | Humectant | - | 2 | - | - | - | - | - | - |
| Lanolin | Emollient | 0.5 | - | - | - | - | - | - | 2 |
| Sodium lauryl ether sulfate cocamide meapearl shine concentrate | Pearlescent | - | - | 10 | 8 | 7 | 10 | 5 | - |
| Sodium chloride (conc. 0.5 mg/mL) | Thickening agent | 4 | - | - | - | - | 2.5 | - | 1 |
| Tween 80 | Solubilizing agent | - | - | 1 | 0.5 | 0.5 | 1 | - | 2 |
| Rice bran oil | Emollient | 2 | - | - | - | - | - | - | - |
| Mineral oil | Emollient | - | - | - | - | - | - | 1 | 1 |
| Wheat protein | Conditioning agent | - | - | - | - | 1 | - | 1 | - |
| Vitamin E | Antioxidant | - | - | - | - | - | 1.5 | - | - |
| Citric acid | Preservative, pH modifier | q.s. | q.s. | q.s. | q.s. | q.s. | q.s. | q.s. | q.s. |
| Water q.s. | Diluent | 100 | 100 | 100 | 100 | 100 | 100 | 100 | 100 |
| Shampoo Formulation | Code |
|---|---|
| Shampoo base | A, B, C, D, E, F, G, H |
| Shampoo containing fermented product | FO2, FO5, FO10 |
| Texapon N70 | N70 |
| Nizoral | C1 |
| Head and shoulder | C2 |
| Clear | C3 |
| Kokliang | C4 |
| Sample | M. furfur 133 | M. furfur 656 | M. furfur 6000 | M. furfur 7966 | ||||
|---|---|---|---|---|---|---|---|---|
| MIC50 (mg/mL) | MFCs (mg/mL) | MIC50 (mg/mL) | MFCs (mg/mL) | MIC50 (mg/mL) | MFCs (mg/mL) | MIC50 (mg/mL) | MFCs (mg/mL) | |
| Ketoconazole | 0.0078 | 0.0078 | 0.25 | 0.25 | 0.0625 | 0.0625 | 0.125 | 0.125 |
| Fermented product | 0.125 | 0.125 | 0.25 | 0.25 | 0.125 | 0.5 | 0.125 | 0.5 |
| Extracts | M. furfur 656 | ||||
|---|---|---|---|---|---|
| Final Concentration (mg/mL) | |||||
| 0.5 | 0.25 | 0.125 | 0.0625 | 0.0312 | |
| Ketoconazole | ![]() | ![]() | ![]() | ![]() | ![]() |
| Fermented product of O. sanctum | ![]() | ![]() | ![]() | ![]() | ![]() |
| Sample | Flash Foam | Maximum Foam | pH | % Solid | Wetting Time (min) | Viscosity |
|---|---|---|---|---|---|---|
| A | 16.67 ± 0.58 | 20.67 ± 0.58 | 7.10 ± 0.02 | 25.78 ± 0.48 | 15.81 ± 0.55 | 0.26 ± 0.03 |
| B | 46.67 ± 2.89 | 62.67 ± 4.62 | 6.17 ± 0.01 | 21.02 ± 0.05 | 32.80 ± 0.55 | 0.66 ± 0.01 |
| C | 46.67 ± 1.53 | 68.33 ± 2.89 | 7.81 ± 0.02 | 28.55 ± 0.37 | 26.58 ± 0.98 | 1.18 ± 0.03 |
| G | 32.33 ± 2.52 | 48.00 ± 2.65 | 8.58 ± 0.02 | 35.11 ± 0.13 | 22.52 ± 1.85 | 1.28 ± 0.07 |
| H | 44.67 ± 1.53 | 56.67 ± 1.53 | 7.32 ± 0.01 | 28.17 ± 0.33 | 18.48 ± 1.54 | 2.32 ± 0.03 |
| C1 | 44.00 ± 1.73 | 59.33 ± 1.15 | 7.39 ± 0.01 | 23.41 ± 0.09 | 21.80 ± 1.94 | 3.91 ± 0.11 |
| C2 | 47.33 ± 2.08 | 65.00 ± 3.00 | 7.64 ± 0.01 | 23.79 ± 0.02 | 32.95 ± 0.83 | 0.83 ± 0.02 |
| C3 | 48.00 ± 2.00 | 70.67 ± 1.15 | 7.41 ± 0.01 | 22.98 ± 0.07 | 37.44 ± 1.24 | 1.42 ± 0.04 |
| C4 | 45.67 ± 2.08 | 59.00 ± 3.61 | 7.48 ± 0.01 | 19.43 ± 0.02 | 24.18 ± 0.68 | 1.22 ± 0.02 |
| Parameter | Shampoo formulation | |||||||
|---|---|---|---|---|---|---|---|---|
| A | B | C | G | H | N70 | C1 | C2 | |
| Smoothness | 3.3 ± 0.9 | 3.8 ± 0.8 | 3.8 ± 0.7 | 3.6 ± 0.6 | 3.4 ± 0.8 | 2.6 ± 0.8 | 3.7 ± 0.9 | 3.5 ± 0.9 |
| Hair shine | 3.1 ± 0.8 | 3.3 ± 0.7 | 3.8 ± 0.8 | 3.5 ± 0.6 | 3.5 ± 0.8 | 2.9 ± 0.6 | 3.5 ± 0.8 | 3.6 ± 0.7 |
| Ease in combing | 3.1 ± 0.8 | 3.2 ± 0.7 | 3.4 ± 0.9 | 3.3 ± 0.7 | 3.4 ± 0.8 | 2.4 ± 1.0 | 3.1 ± 1.0 | 3.5 ± 1.0 |
| Frizz reduction | 3.2 ± 0.7 | 3.0 ± 0.8 | 3.6 ± 0.7 | 3.8 ± 0.6 | 3.3 ± 0.6 | 2.4 ± 0.8 | 3.2 ± 0.9 | 3.6 ± 0.7 |
| Tribolectric reduction | 3.1 ± 0.9 | 3.3 ± 0.9 | 3.7 ± 0.9 | 3.5 ± 0.7 | 3.3 ± 0.9 | 2.4 ± 0.8 | 3.0 ± 0.9 | 3.1 ± 1.0 |
| Sample | Inhibition Zone (mm) | |||
|---|---|---|---|---|
| M. furfur 133 | M. furfur 656 | M. furfur 6000 | M. furfur 7966 | |
| C | 7.3 ± 0.6 | 7.0 ± 0.0 | 16.0 ± 1.0 | 14.6 ± 0.8 |
| C1 | 34.5 ± 1.4 | 37.7 ± 1.4 | 31.3 ± 1.3 | 34.3 ± 1.3 |
| C2 | 38.2 ± 0.5 | 39.4 ± 0.5 | 33.1 ± 0.9 | 37.6 ± 1.9 |
| FO2 | 13.2 ± 1.6 a | 12.8 ± 1.1 a | 18.7 ± 0.3 a | 17.0 ± 1.1 a |
| FO5 | 12.1 ± 0.3 a | 12.4 ± 0.3 a | 16.7 ± 2.3 a | 15.0 ± 1.6 a |
| FO10 | 16.1 ± 1.5 b | 14.6 ± 1.4 b | 17.2 ± 0.5 a | 16.2 ± 1.3 a |
© 2018 by the authors. Licensee MDPI, Basel, Switzerland. This article is an open access article distributed under the terms and conditions of the Creative Commons Attribution (CC BY) license (http://creativecommons.org/licenses/by/4.0/).
Share and Cite
Punyoyai, C.; Sirilun, S.; Chantawannakul, P.; Chaiyana, W. Development of Antidandruff Shampoo from the Fermented Product of Ocimum sanctum Linn. Cosmetics 2018, 5, 43. https://doi.org/10.3390/cosmetics5030043
Punyoyai C, Sirilun S, Chantawannakul P, Chaiyana W. Development of Antidandruff Shampoo from the Fermented Product of Ocimum sanctum Linn. Cosmetics. 2018; 5(3):43. https://doi.org/10.3390/cosmetics5030043
Chicago/Turabian StylePunyoyai, Chanun, Sasithorn Sirilun, Panuwan Chantawannakul, and Wantida Chaiyana. 2018. "Development of Antidandruff Shampoo from the Fermented Product of Ocimum sanctum Linn." Cosmetics 5, no. 3: 43. https://doi.org/10.3390/cosmetics5030043
APA StylePunyoyai, C., Sirilun, S., Chantawannakul, P., & Chaiyana, W. (2018). Development of Antidandruff Shampoo from the Fermented Product of Ocimum sanctum Linn. Cosmetics, 5(3), 43. https://doi.org/10.3390/cosmetics5030043